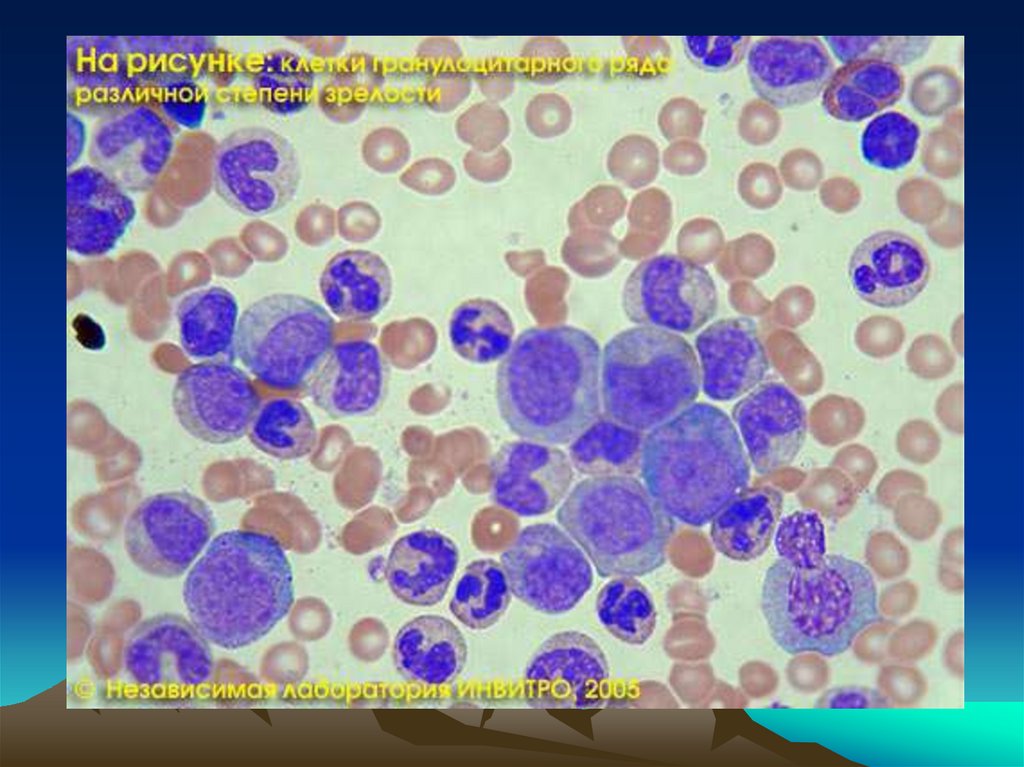
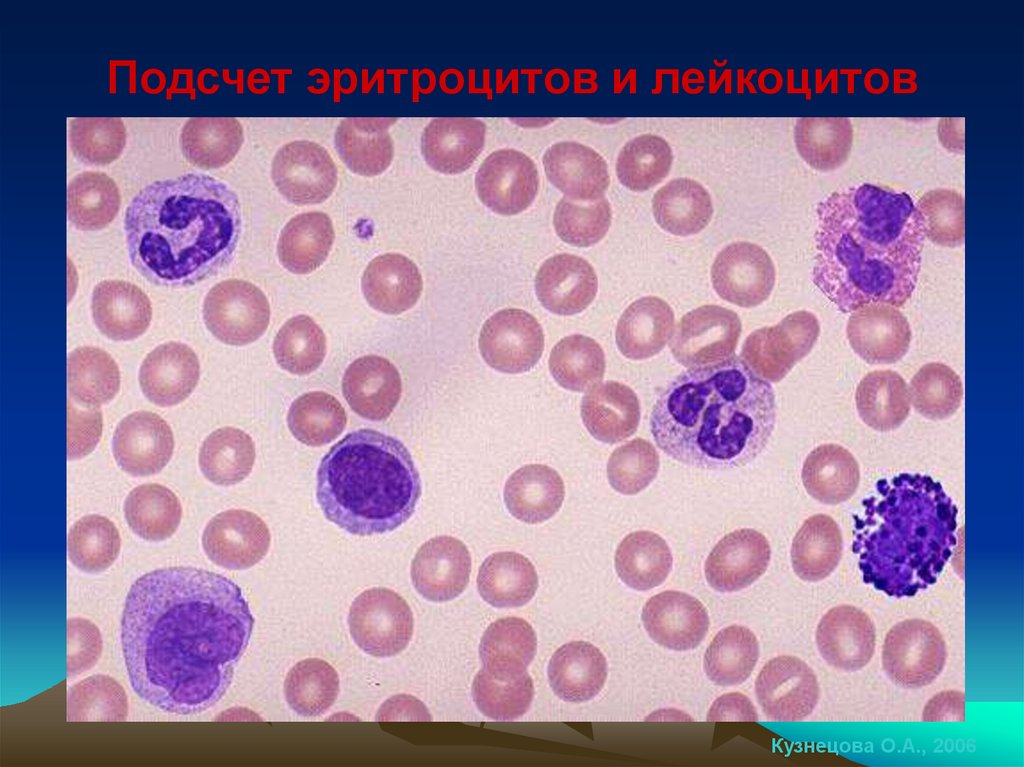
Подсчет эритроцитов и лейкоцитов
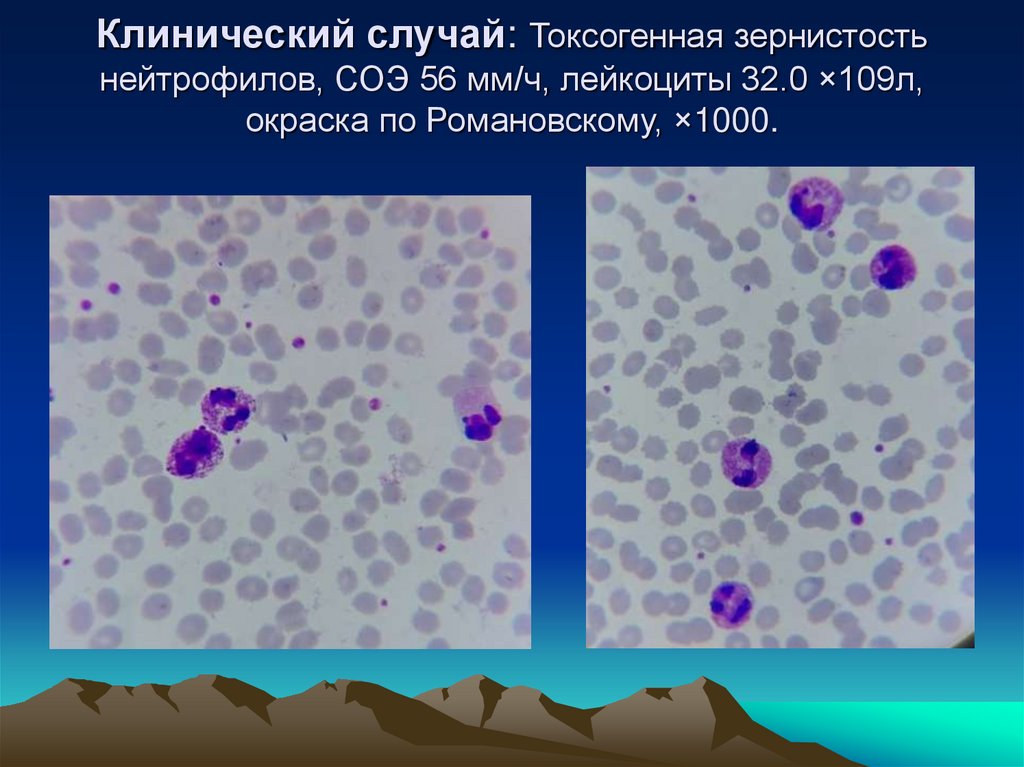
Клинический случай: Токсогенная зернистость нейтрофилов, СОЭ 56 мм/ч, лейкоциты 32.0 ×109л, окраска по Романовскому, ×1000.
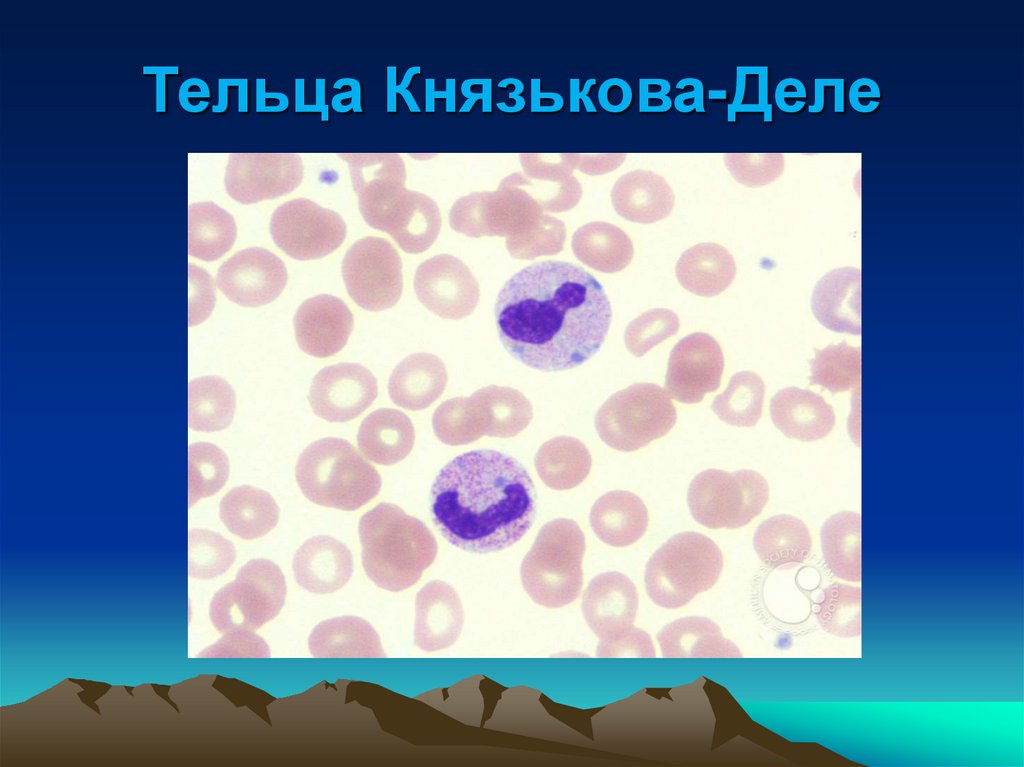
Тельца Князькова-Деле
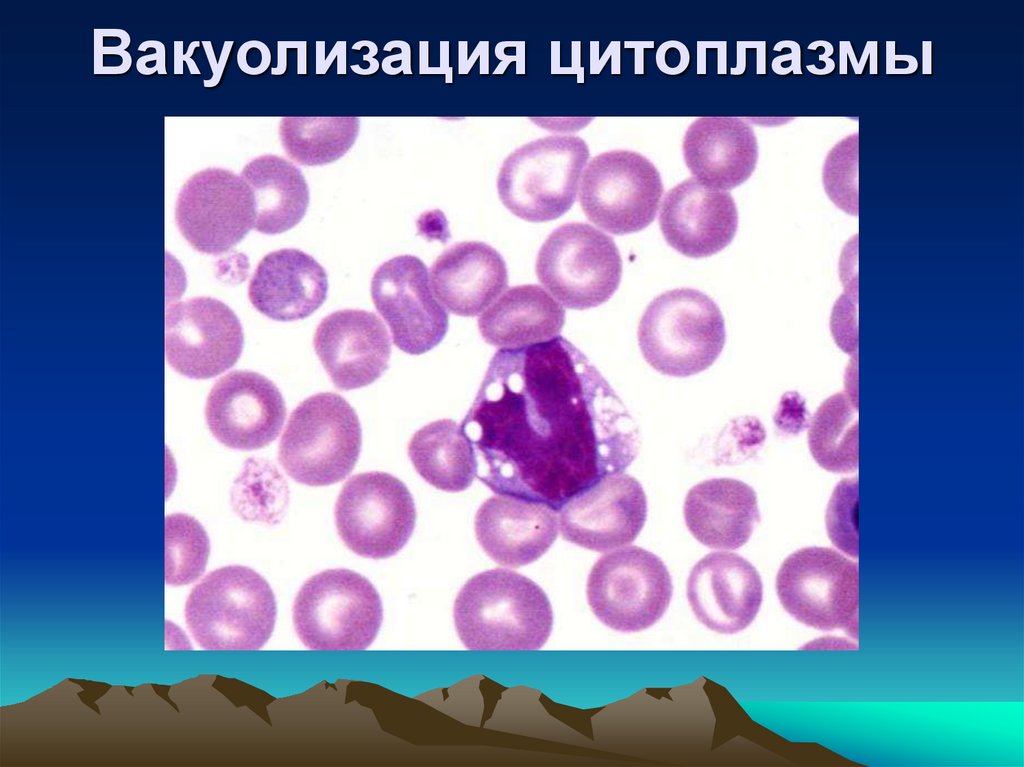
Вакуолизация цитоплазмы
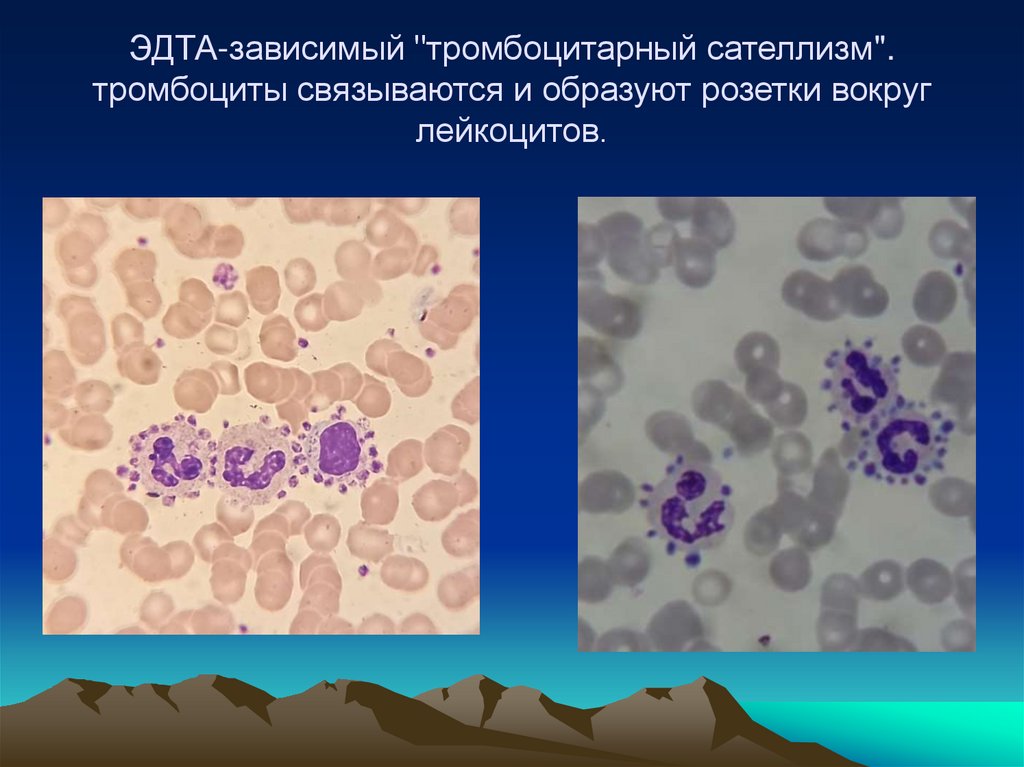
ЭДТА-зависимый "тромбоцитарный сателлизм". тромбоциты связываются и образуют розетки вокруг лейкоцитов.

Similar presentations:
Интерпретация клинического анализа крови
1.
Интерпретацияклинического анализа
крови
Преподаватель: Никитина А.Н.
2.
• Постоянство внутренней среды организма залог свободной и независимой жизни.• Клод Бернар
• Кровь - это жидкая ткань, циркулирующая
по сосудам, осуществляющая транспорт
различных веществ в пределах организма и
обеспечивающая питание и обмен веществ
всех клеток тела.
• Учение о крови и ее болезнях называется
гематологией.
• В понятие «система крови» входят: кровь,
органы
кроветворения
и
органы
кровообращения.
3. ГЕМОГРАММА
WBC (white blood cells)-лейкоцитыRBC (red blood cells) – эритроциты
HGB (hemoglobin) – гемоглобин
HCT (hematocrit) – гематокрит
MCV – средний объем эритроцита
MCH – среднее содержание
гемоглобина в эритроцитах
4.
MCHC – средняя концентрациягемоглобина в эритроците
RDW – отражает размер эритроцита
(анизоцитоз)
PLT (platelet) – количество
тромбоцитов
MPV – средний объем тромбоцитов
PDW – степень анизоцитоза
тромбоцитов
PCT - тромбокрит
5.
LYM или LY – лимфоцитыGRN или GR – гранулоциты
MON или MO - моноциты
6. ГЕМАТОЛОГИЧЕСКИЕ ИССЛЕДОВАНИЯ КРОВИ
Общеклиническое исследование крови• Общеклиническое
исследование
крови,
являясь
одним
из
важнейших
диагностических методов, тонко отражает
реакцию
кроветворных
органов
на
воздействие
на
организм
различных
физиологических и патологических факторов.
• Во многих случаях оно играет большую роль
в постановке диагноза, а при заболеваниях
системы кроветворения ему отводится
ведущая роль.
7. В понятие «общеклиническое исследование крови» входят :
определение концентрации гемоглобина,
подсчет количества эритроцитов,
расчет цветового показателя,
подсчет количества лейкоцитов,
определение скорости оседания эритроцитов (СОЭ)
подсчет лейкоцитарной формулы.
Дополнительные методы исследования:
* время свертывания крови,
* длительность кровотечения,
*подсчет количества ретикулоцитов,
* подсчет количества тромбоцитов.
8. Капиллярная кровь. Для исследований клеточного состава капиллярную кровь рекомендуется брать в следующих случаях:
- при необходимости ежедневного мониторингаза показателями крови;
- - при ожогах, занимающих большую площадь
поверхности тела пациента;
- при наличии у пациента мелких или
труднодоступных вен;
- при выраженном ожирении пациента;
- при установленной склонности к венозному
тромбозу;
- у новорожденных
9.
• Для взятия пробы капиллярной кровииспользуют стерильные скарификаторыкопья
одноразового
применения
или
лазерные перфораторы.
• Между объемом получаемой крови и
глубиной
прокола
имеется
прямая
зависимость.
• В связи с этим скарификатор следует
выбирать в зависимости от места прокола и
количества
крови,
необходимого
для
выполнения различных исследований.
10.
• Пункцию пальца не следует проводить умладенцев, так как это может привести к
повреждению кости. У новорожденных
кровь берут из пятки, при этом
рекомендуется
использовать
специальные
атравматичные
скарификаторы.
11.
- Применение ватных тампонов и другихволокнистых материалов не рекомендовано,
поскольку
это
приводит
к
засорению
волокнами счетных и гемоглобиновой камер.
(В результате точность измерения снижается)
- Первую каплю крови, полученную после
прокола кожи, следует удалить тампоном,
поскольку эта капля содержит примесь
тканевой жидкости.
- Капли крови должны свободно вытекать,
нельзя давить на палец и массировать зону
вокруг прокола, так как при этом в кровь
попадает тканевая жидкость, что существенно
искажает результаты исследования.
12.
- При прикосновении края пробирки к меступункции капли крови начинают стекать в нее
под действием капиллярного эффекта.
- После завершения сбора крови пробирку
следует плотно закрыть.
- Необходимым условием для обеспечения
качественной пробы является ее обязательное
немедленное
перемешивание
с
антикоагулянтом путем (в зависимости от
формы пробирки) осторожного встряхивания
или переворачивания пробирки 10 раз.
- В случае последовательного взятия капиллярной
крови в несколько микропробирок необходимо
соблюдать определенный порядок их заполнения.
13.
Дляисследования
основных
показателей
крови
используются
автоматизированные
аппараты.
Пробирка
с
кровью
тщательно встряхивается,
чтобы не было сгустков.
Пробирка помещается в
анализатор и
через
короткое время
все
показатели выводятся на
монитор, а затем на
принтер.
14.
Кровь состоит из жидкой части (плазмы) ивзвешенных в ней форменных
элементов:
• эритроцитов,
• лейкоцитов
• тромбоцитов (кровяных пластинок).
Форменные элементы составляют
41-45% объема крови у женщин и 44-48% у мужчин (эту величину называют
гематокрит).
15. Форменные элементы крови
16. Мазок крови
17. Лейкоцитарная формула — это процентное соотношение отдельных видов лейкоцитов.
• Если общее количество всех лейкоцитов принять за100 %, то в норме будет наблюдаться следующее
соотношение (%):
• • базофилы
— 0- 1
• • эозинофилы — 0,5 - 5
• • нейтрофилы:
• палочкоядерные
— 1-6
• сегментоядерные
— 49-72
• • лимфоциты
— 19-37
• • моноциты
— 3-11
18.
19.
20.
21.
22.
23.
24.
25. Подсчет эритроцитов и лейкоцитов
Кузнецова О.А., 200626.
В зависимости от наличия в цитоплазмелейкоцитов специфической зернистости
их разделяют на:
• гранулоциты (нейтрофилы,
эозинофилы, базофилы
• агранулоциты (лимфоциты и
моноциты).
27. WBC - Лейкоциты – «белые кровяные тельца» - гетерогенная популяция ядросодержащих клеток
WBC - Лейкоциты – «белые кровяные тельца» гетерогенная популяция ядросодержащих клеток•Нейтрофилы
Эозинофил
Базофил
Клетки крови
• Гранулоциты:
• Базофилы
• Эозинофилы
• Нейтрофилы
• Агранулоциты:
• Моноциты
• Лимфоциты
Моноцит
Лимфоцит
28.
• Исследованиелейкоцитарной
формулы
имеет большое диагностическое значение,
указывая
на
характерные
для
ряда
заболеваний изменения. Но все данные
должны оцениваться в связи с общим
количеством лейкоцитов, принимая во
внимание, что важны только абсолютные, а
не относительные величины.
• В крови практически здорового человека (в
норме) содержится лейкоцитов:
• 4 х 109/л – 9,0 х 109/л.
• Изменение числа лейкоцитов, содержащихся
в крови, имеет большое значение для
диагностики и прогноза ряда заболеваний,
особенно при инфекционных заболеваниях и
заболеваниях крови.
29.
• Картину белой крови при различныхзаболеваниях определяет совокупность
следующих признаков:
• 1. Общее число лейкоцитов.
• 2. Наличие ядерного сдвига
нейтрофилов.
• 3. Процентное соотношение отдельных
лейкоцитов.
• 4. Наличие или отсутствие
дегенеративных изменений в клетках.
30. Нарушение нормального соотношения среди нейтрофилов
• В этом изменении нормальногопроцентного соотношения между
клетками нейтрофильного ряда
различают:
• 1.Ядерный сдвиг нейтрофилов влево —
характеризуется появлением в гемограмме
молодых и дегенеративных форм
нейтрофилов, что наблюдается при:
• • инфекционных заболеваниях;
• • воспалительных процессах;
• • злокачественных новообразованиях;
• • интоксикациях.
31.
32.
• Отношение суммы всех несегментированныхформ нейтрофилов к сегментированным
называется «индексом сдвига» нейтрофилов
и определяется по следующей формуле:
• Индекс сдвига = М + Ю + П
-----------------С
• Где: М — миелоциты, Ю — юные
нейтрофилы,
• П — палочкоядерные, С — сегментоядерные
нейтрофилы.
33.
• В норме индекс сдвига равен 0,05—0,08. Тяжесть степени заболевания по
индексу сдвига:
• • тяжелая степень — индекс от 1,0 и
выше;
• • средней степени — индекс 0,3—1,0;
• • легкая степень — индекс не более 0,3.
34.
• 2. Ядерный сдвиг нейтрофилов вправо —среди нейтрофилов преобладают зрелые
формы с 5—6 сегментами вместо обычных
трех.
• Индекс сдвига — менее 0,04.
• Ядерный сдвиг нейтрофилов вправо
встречается:
• • в норме у 20 процентов практически
здоровых людей;
• • при лучевой болезни.
• Ядерный сдвиг нейтрофилов вправо при
инфекционных и воспалительных
заболеваниях указывает на благоприятное
течение.
35.
• Каждая из клеток крови выполняетопределенные функции, совокупность
которых обеспечивает нормальную
жизнедеятельность организма.
36. Общее количество лейкоцитов (в норме 4 - 9 на10*9)
• Лейкоцитоз — повышение общегоколичества лейкоцитов в крови отмечается
при:
• • острых инфекционных заболеваниях;
• • гнойно-септических процессах;
• • коматозных состояниях (уремическая,
диабетическая и печеночная кома);
• • интоксикациях (пищевая, мышьяковистым
водородом, хинином, угарным газом,
нитробензолом);
• • злокачественных новообразованиях;
• • инфаркте миокарда;
• • гемолитических кризах;
• • эпилепсии;
37.
заболеваниях системы кроветворения:• • лимфогранулематозе;
• • лейкозах;
• • после обильных кровопотерь;
• • в результате введения некоторых
лекарственных средств (камфара,
адреналин, инсулин);
различных физиологических состояниях:
• • беременность с 5—6-го месяца;
• • период лактации;
• • предменструальный период;
• • после тяжелых физических или психических
нагрузок.
38.
• Лейкопения — уменьшение общего числалейкоцитов в крови наблюдается при:
• • некоторых инфекционных заболеваниях
(брюшной
тиф,
малярия,
бруцеллез,
затяжной септический эндокардит, грипп,
корь, вирусный гепатит);
• • коллагенозах (СКВ — системная красная
волчанка);
• • тяжелом течении воспалительных и гнойносептических
заболеваний
(лейкоцитоз
сменяется лейкопенией);
• • воспалительных и гнойно-септических
заболеваниях у пожилых и истощенных лиц;
• • остром лейкозе (в 50 % случаев);
39.
• гипопластических состояниях:• • хроническая интоксикация бензолом;
• • лучевая болезнь;
• • лекарственные воздействия (амидопирин,
сульфаниламиды, барбитураты, производные
тиоурацила, цитостатики);
• • гастриты, колиты, холецистоангиохолиты,
эндометриты — за счет повышенного
выведения лейкоцитов из организма;
• • эндокринные заболевания;
• • реже — тиреотоксикоз;
• • функциональные заболевания ЦНС
(центральной нервной системы).
40. Эритроциты
Эритроциты участвуют:в тканевом дыхании (перенос кислорода от
органов дыхания к клеткам организма с
участием гемоглобина);
в доставке питательных
веществ(аминокислот, липидов) к
клеткам и тканям, выполняя
питательную функцию.
Выполняют защитную функцию,
связывают токсины и переносят на
своей поверхности антитела.
Принимают участие в процессе
свертывания крови.
41. Эритроциты — безъядерные форменные элементы красной крови, содержащие гемоглобин. Продолжительность жизни эритроцитов от 90 до
120 дней.• Эритроциты в норме представляют собой
двояко-вогнутые диски в диаметре 7-8 микрон
(нормоцит)
• Содержание эритроцитов в норме по
возрастам и полу составляет:
• • новорожденные - (3,9-5,5) х 1012/л;
• • дети 2 месяцев - (2,7-4,9) х 1012/л;
• • дети 6-12 лет
- (4,0-5,2) х 1012/л;
• • мужчины
- (4,0-5,1) х 1012/л;
• • женщины
- (3,7-4,7) х 1012/л.
42.
• Уменьшение количества эритроцитов(эритропения) характерно для анемии.
• Увеличение числа эритроцитов
(эритоцитоз, полицетемия) наблюдается
при:
• сердечно-сосудистых заболеваниях;
• острых отравлениях;
• ацидозах;
• потере жидкости (относительная
полицетемия).
43. Гемоглобин — основное белковое вещество крови
• Определение гемоглобина в кровиявляется одним из основных методов
лабораторного исследования. Одной из
основных задач гемоглобина является
перенос кислорода из легких в органы и
ткани организма, что обеспечивает
энергетические процессы в организме.
44.
• Норма содержания гемоглобина в кровиварьирует в зависимости от возраста и
пола (г/л):
• • новорожденные — 210;
• • дети 2—4 недели — 170,6;
• • дети 1—3 месяца — 132,6;
• • дети 4—6 месяцев — 129,2;
• • дети 7—12 месяцев — 127,5;
• • старше 2 лет — 116-135;
• • мужчины — 132—164;
• • женщины — 115—145.
45. Повышенное содержание гемоглобина встречается редко при:
• • эритремии;• • сердечно-сосудистых декомпенсациях;
• Относительное повышение концентрации
гемоглобина в крови наступает при значительной
потери организмом человека жидкости.
– Уменьшение содержания общего
количества гемоглобина в крови.
• Анемия (малокровие)
• Основные группы анемий :
• I. По причине возникновения – 3 группы:
1. Постгеморрагические – вследствие кровопотерь.
2. Анемии, обусловленные нарушением кровообразования.
3. Анемии, вследствие усиленного кроворазрушения –
гемолитические.
(
46. Цветовой показатель
• Является показателем степени насыщенияэритроцитов гемоглобином и отражает
соотношение
между
количеством
эритроцитов и гемоглобина в крови.
• В норме цветовой показатель = 0,85—1,15.
• В зависимости от цветового показателя
анемии делятся на:
• • гипохромные — цветовой показатель < 0,85;
• • нормохромные — цветовой показатель =
0,85—1,15;
• • гиперхромные — цветовой показатель >
1,15.
47. Скорость оседания эритроцитов (СОЭ)
Скорость оседания эритроцитов
(СОЭ)
СОЭ является одним из важных и наиболее
распространенных лабораторных
исследований крови.
• В норме возрастные показатели СОЭ
следующие (по микрометоду Панченкова - в
мм/ч):
1. • у новорожденных — 1 мм/ч;
2. • до 1 месяца — 2—6 мм/ч;
3. • детей 6—12 месяцев — 4-14 мм/ч;
4. • детей 2—10 лет —4-12 мм/ч;
5. • мужчин
— 1-10 мм/ч;
6. • женщин
— 2-15 мм/ч.
7. пожилых -- до 20 мм/ч
48. Ускоренная СОЭ отмечается при:
• инфекционных заболеваниях;
• • заболеваниях, сопровождающихся
воспалительными процессами;
• • злокачественных опухолях;
• • почечных заболеваниях;
• • парапротеинемии (миелома, макроглобулинемия,
атипичные лейкозы);
• • заболеваниях печени;
• • анемии (кроме микросфероцитарной и
дрепаноцитной).
При заболеваниях сердечно-сосудистой системы
часто отмечается замедление СОЭ с
приближением к нижней границе нормы за счет
полицетемии и повышенной концентрации
углекислого газа в крови.
49. Правила исследования СОЭ, основные причины ошибок анализа
• Исследование - при 18-25°C. При более высоких температурах СОЭувеличивается, при низких – замедляется.
• Исследование СОЭ - не позже 2 часов после взятия крови.
• Если кровь охлаждалась до +4°C, СОЭ можно определять в
течение 6 часов, но перед анализом кровь должна быть прогрета до
комнатной температуры.
• При отсутствии резкой границы между эритроцитным столбиком и
плазмой (светлая «вуаль» из разведенных эритроцитов и ретикулоцитов) определяется граница компактного слоя, а эритроцитарная
вуаль причисляется к столбику плазмы.
Искажение результатов возможно при:
• нарушении соотношения кровь / цитрат,
• пребывании пробы с цитратом на свету / в тепле более 4 часов,
• определении в пробирке / капилляре под наклоном,
• использовании пробирок / капилляров из пластика (полипропилен,
поликарбонат). Лучше применять стеклянные капиллярные пипетки.
Луговская С.А., 2007
50. Гематокрит
• Общий объем эритроцитов (гематокритная величина)дает представление о процентном соотношении
между плазмой и форменными элементами.
Гематокрит в норме:
• у мужчин - 40-48 %;
• у женщин - 36-42 %.
Объем эритроцитов увеличивается при:
• обезвоживании (токсикозы, поносы, рвоты);
• врожденные пороки сердца, сопровождающиеся
цианозом;
• полицетемии;
• недостаточности коры надпочечников.
Объем эритроцитов уменьшается при:
• анемии.
51. Ретикулоциты
• Это молодые формы эритроцитов, содержащиезернистые сетчатые включения, выявляемые с
помощью специальных прижизненных методов
окраски.
• В норме содержание ретикулоцитов в крови
составляет:
• 0,2-1,2 % / 2-12 %о
• Ретикулоцитоз наблюдается при:
• • анемиях,
• • полицетемии,
• • малярии.
• Снижение количества ретикулоцитов или их
отсутствие является плохим прогностическим
признаком при анемиях, указывая на утраченную
регенеративную способность костного мозга в
отношении эритроцитов.
52. Тромбоциты
• Кровяные пластинки, являются осколками цитоплазмымегакариоцитов. В сосудистом русле располагаются вдоль
стенок сосудов, в малоподвижном слое плазмы, богатом
фибриногеном. Эритроциты движутся в центре сосуда. Такое
краевое стояние тромбоцитов предотвращает выход эритроцитов
за пределы сосудистой стенки.
• Функция тромбоцитов:
• Участвуют в процессе гемостаза (остановка кровотечения).
• Обладают способностью к агрегации и адгезии (могут
склеиваться между собой, группироваться и прилипать к
поврежденной поверхности сосуда, при этом образуется
первичная тромбоцитарная пробка, останавливающая
кровотечение).
• Содержат большое количество ферментов, с действием которых
связана их биологическая активность, т . е. способны
поддерживать спазм поврежденных сосудов, принимают участие
в процессе свертывания крови.
• Продолжительность жизни тромбоцитов 7 – 10 дней.
53. Повышение числа тромбоцитов в крови (тромбоцитоз)
• может быть:• первичным, т.е. являться результатом первичной
пролиферации мегакариоцитов,
• и вторичным, реактивным, возникающим на фоне
какого-либо заболевания.
• 1. Тромбоцитозы первичные: при эритремии,
хроническом миелолейкозе и миелофиброзе.
• 2. Тромбоцитозы вторичные: при остром
ревматизме, ревматоидном артрите, туберкулезе,
циррозе печени, язвенном колите, остеомиелите,
амилоидозе, остром кровотечении,
лимфогранулематозе, лимфоме, состоянии после
спленэктомии (в течение 2 мес и более), остром
гемолизе, после операций (в течение 2 нед).
54. Снижение числа тромбоцитов в крови
• Физиологические колебания количества тромбоцитов в крови втечение суток — примерно 10 %. У женщин во время менструации
количество тромбоцитов может уменьшиться на 25—50 %.
• 1. Тромбоцитопении, связанные со снижением
образования тромбоцитов (недостаточность
кроветворения).
• Приобретенные:
• вирусные инфекции (вирусный гепатит, аденовирусы);
• интоксикации (ионизирующее облучение,
миелодепрессивные химические вещества и
препараты, некоторые антибиотики, уремия, болезни
печени);
• опухолевые заболевания (острый лейкоз, метастазы
рака и саркомы в костный мозг; миелофиброз и
остеомиелосклероз);
• мегалобластные анемии (дефицит витамина В12 и
фолиевой кислоты);
55.
• 2. Тромбоцитопении, обусловленныеповышенной деструкцией тромбоцитов.
• Аутоиммунные — идиопатическая (болезнь
Верльгофа) и вторичные (при системной красной
волчанке, хроническом гепатите, хроническом
лимфолейкозе и др.), у новорожденных в связи с
проникновением материнских аутоантител во
внутреннюю среду организма ребенка.
• Изоиммунные (неонатальная, посттрансфузионная).
• Гаптеновые (гиперчувствительность к некоторым
лекарствам).
• Связанные с вирусной инфекцией.
• Связанные с механическим повреждением
тромбоцитов: при протезировании клапанов сердца.
• 3. Тромбоцитопении, связанные с повышенным
потреблением тромбоцитов: синдром
диссеминированного внутрисосудистого свертывания
крови, тромбоцитопеническая пурпура и др.
56.
Возможные причины ошибок приавтоматическом подсчете тромбоцитов
Ложное занижение числа тромбоцитов - вследствие:
• агрегации или агглютинации тромбоцитов при наличии тромбоцитарных агглютининов и прилипании тромбоцитов к лейкоцитам
(тромбоцитарный "сателлизм").
• наличия аутоантител к тромбоцитам. ЭДТА индуцирует агрегацию
ТЦ => псевдотромбоцитопения.
Луговская С.А., 2009
57. RBC (эритроциты)
В нормеколичество
эритроцитов
составляет
3,9х10 /л5,0xl0 /л
12
12
58. Возможные ошибки измерения количества эритроцитов
Ложное завышение результатов:• при криоглобулинемии;
• в присутствии гигантских тромбоцитов (MPV > 30 fl);
• при гиперлейкоцитозе ( 50-100 х 109/л); особенно с
анемией ( MCV, MCHC)
Ложное занижение результатов:
• при агглютинации эритроцитов ( MCV, MCHC);
• при выраженном микроцитозе ( 36 фл);
• при наличии сгустков или гемолиза in vitro.
Луговская С.А., 2007
59. Гематокрит (HCT)
• Показатель гематокрита даетпредставление о соотношении между
объемом плазмы и эритроцитами
• Наиболее точным и удобным является
автоматическое определение
гематокрита
• У здорового человека гематокрит
венозной и капиллярной крови
составляет 0,35-0,50 мкл.
60. По характеру ядерного сдвига нейтрофилов различают:
• а) регенеративный сдвиг — при которомувеличивается количество палочкоядерных
(П) и юных (Ю) нейтрофилов на фоне
лейкоцитоза, что является показателем
повышенной деятельности костного мозга;
наблюдается при воспалительных и гнойносептических процессах,
• б) дегенеративный сдвиг — отмечается
увеличение количества только
палочкоядерных нейтрофилов и появление
дегенеративных изменений в клетках. Это
является показателем функционального
угнетения костного мозга.
• Может протекать как с лейкоцитозом,
так и с лейкопенией.
61.
• Дегенеративный сдвиг на фонелейкоцитоза характерен для:
• • сальмонеллеза;
• • токсической дизентерии;
• • острого перитонита;
• • уремической и диабетической комы.
Дегенеративный сдвиг на фоне
лейкопении характерен для:
• • вирусных инфекций;
• • тифопаратифозных заболеваний.
62.
• в) лейкемоидные реакциихарактеризуются появлением незрелых
форм: миелоцитов (М), промиелоцитов
и даже миелобластов на фоне
выраженного лейкоцитоза.
• Характерны для:
• • инфекционных болезней;
• • туберкулеза;
• • злокачественных новообразований
(рак желудка, молочной железы,
толстой кишки).
63. Строение и функции белых клеток крови — лейкоцитов
Основные функциилейкоцитов:
• Лейкоциты, встречающиеся не только в
крови, но и в лимфе, называются
лимфоцитами.
64. Лимфоциты —
• вырабатываютособый
вид
белков,
называемый
антителами,
который
обезвреживает попадающие в организм
чужеродные вещества и их яды.
• Одни антитела могут иметь избирательное
действие только против возбудителя одного
заболевания (например, кори), а другие
имеют более широкий спектр действия
против возбудителей нескольких заболеваний
одновременно.
• Антитела могут сохраняться длительное
время в организме человека, повышая его
невосприимчивость
к
повторным
заболеваниям и общую сопротивляемость
организма.
65.
• Лимфоцитоз — увеличение количествалимфоцитов в крови, делится на:
• а) физиологический лимфоцитоз:
• • возрастная норма для детей;
• • после физической нагрузки;
• •при
потреблении
пищи,
богатой
углеводами;
• • в период менструации;
66.
• б) патологический лимфоцитоз —• острый лейкоз и хронический лимфолейкоз;
• • при инфекционных заболеваниях;
• • хроническом туберкулезе;
• • вторичном сифилисе;
• • при бронхиальной астме;
• голодании;
• • В12-дефицитной анемии;
• • при эндокринных заболеваниях;
• • гипофункция яичников.
67.
• Лимфопения - понижение количествалимфоцитов в крови, наблюдается при:
• • тяжелом лечении инфекционных,
воспалительных и гнойно-септических
заболеваниях;
• • лучевой болезни.
68. Моноциты
• Обладают значительной подвижностью.Это фагоциты крови (греч. «фагос» —
поглощающий)
т.
е.
клетки,
«пожирающие»
более
крупные
чужеродные частицы, их остатки,
иногда целые клетки.
• В частности, моноциты поглощают
малярийные плазмодии, микобактерии
туберкулеза и т.д.
69.
• Моноцитоз—
увеличение
количества
моноцитов в крови, наблюдается при:
• • острых инфекционных заболеваниях;
• • хроническом течении инфекций (малярии,
бруцеллезе, висцеральном лейшманиозе,
туберкулезе);
• • злокачественных опухолях;
• •остром моноцитарном лейкозе (до 70 %
моноцитов в крови).
• Моноцитопения — уменьшение количества
моноцитов в крови, отмечается при:
• • тяжелых септических процессах;
• • инфекционных заболеваниях (брюшной тиф
и др.).
70.
• Базофилия — увеличение количествабазофилов в крови.
• Базофилы содержат в своих гранулах
важнейшие медиаторы тканевого обмена
(гепарин,
гистамин)
и
участвуют
в
аллергических, воспалительных реакциях, а
также в процессе свертывания крови.
• Базофилия отмечается при:
• • острой иммунотромбоцитопении;
• • гипотиреозе;
• • хроническом миелолейкозе.
71.
• Эозинофилы, их функция:• Участвуют в аллергических реакциях, что
обусловлено
содержанием
в
клетках
эозинофилов антигистаминного вещества. Это
ферменты,
инактивирующие
вещества,
возникающие при проявлении аллергии.
• Образуют
антитоксины,
обезвреживающие
продукты жизнедеятельности бактерий.
• Обладают способностью к фагоцитозу.
• Выполняют
транспортную
функцию
–
адсорбируют на своей поверхности продукты
распада белков, являющихся антигенами,
переносят
их
к
лимфатическим
узлам,
способствуя выработке антител.
72.
Эозинофилия — увеличение количестваэозинофилов в крови является своеобразной
реакцией
организма
на
поступление
чужеродного белка и гистамина.
• Эозинофилия отмечается при:
• паразитарных заболеваниях;
• аллергозах
(аллергические
заболевания
различной локализации (бронхиальная астма,
дерматозы,
сенная
лихорадка,
пищевая
аллергия)).
• коллагенозах (ревматизм, дерматомиозит);
• лечении антибиотиками, сульфаниламидами;
• заболевании системы крови;
73.
• ожоговой болезни, отморожениях;• некоторых эндокринных заболеваниях (гипотиреозе);
• при инфекционных заболеваниях в период развернутой
клинической картины – скарлатина, инфекционный
мононуклеоз, гонорея.
• при всех воспалительных заболеваниях, аутоиммунных
процессах,
злокачественных
новообразованиях,
хронических
инфекциях
(туберкулезе),
кожных
заболеваниях (экзема, псориаз, пузырчатка, герпес,
микозы),
в
процессе
которых
присоединяется
аллергический компонент, определяемый гиперпродукцией
IgE.
• в фазе выздоровления от инфекционных заболеваний.
• Эозинопения и анэозинофилия — уменьшение
количества или полное отсутствие эозинофилов в крови,
встречается при:
• • брюшном тифе;
• • на высоте некоторых острых инфекций;
74. Нейтрофилы —
• как и моноциты, обладают фагоцитарной активностью.Выполняют:
Бактерицидную;
Вирусоцидную;
дезинтоксикационную функции в организме.
Они способны переваривать с помощью ферментов
захваченные бактерии, вирусы, грибы и др. частицы,
обеззараживают организм человека.
• Эти клетки могут самостоятельно передвигаться,
выходить из кровяного русла в окружающие ткани,
перемещаться между клетками, проникать через
клеточные
мембраны,
направляясь
к
очагу
воспаления. Они участвуют во всех этапах
воспалительного процесса.
75. Дегенеративные изменения лейкоцитов
76.
• Дегенеративныеизменения
лейкоцитов
—
приобретеные
аномалии
в
видимой
структуре
лейкоцитов,
появляющиеся
при
различных патологических состояниях
приводящих к интоксикации организма.
Например:
инфекции,
химическое
отравление, действие ионизирующего
излучения, распад опухолевой ткани.
77. Токсогенная зернистость нейтрофилов (ТЗН)
• Качественное изменение лейкоцитов,представляет собой темные крупные
грубые гранулы внутри лейкоцита,
образующиеся в результате физикохимических
изменений
белковой
структуры жидкой части цитоплазмы —
коагуляции
белка
под
влиянием
продуктов интоксикации и агломерации
белка, вокруг обычных нейтрофильных
зерен. Белок как бы сваривается в
процессе воспаления.
78.
79. Клинический случай: Токсогенная зернистость нейтрофилов, СОЭ 56 мм/ч, лейкоциты 32.0 ×109л, окраска по Романовскому, ×1000.
80.
• ТЗН характерна:• для интоксикаций организма при
гнойных процессах;
• воспалительных
процессов
кокковой этиологии;
• распаде опухолевой ткани;
• действии ионизирующей радиации.
81. Тельца Князькова-Деле
• Крупныебледно-голубые
комочки
различной
формы
в
цитоплазме
нейтрофилов, представляющие собой
РНК
и
фрагменты
шероховатого
эндоплазматического ретикулума.
• Наблюдаются:
• при скарлатине сепсисе;
• кори;
• пневмонии ожогах.
82. Тельца Князькова-Деле
83. Зерна Амато
• Небольшие округлые овальные илитипа запятой образования красящиеся в
бледно-голубой
цвет;
в
них
наблюдаются красные или краснофиолетовые зерна.
• Описаны зерна Амато:
• при скарлатине;
• но
встречаются
и
при
других
инфекциях. Близки к тельцам Деле.
84.
85. Вакуолизация цитоплазмы
• Появление вакуолизации указывает:• на тяжесть заболевания;
• и интоксикации.
• наиболее характерна для тяжелейших
форм сепсиса, абсцессов, острой
дистрофии печени.
• Иногда наблюдается почти тотальная
вакуолизация
всех
лейкоцитов:
«дырявые»,
«простреленные»
лейкоциты.
86. Вакуолизация цитоплазмы
87. Вакуолизация цитоплазмы
88.
Изменение размеров и формылейкоцитов
• Анизоцитоз
лейкоцитов
—
встречаются
лейкоциты
различной
формы. Признак тяжелого токсикоза при
сепсисе,
туберкулеза,
пернициозной
анемии.
• Сморщивание клетки — микроформы
лейкоцитов.
• Несоответствие
развития
ядра
и
цитоплазмы
—
ядро
нейтрофила
зрелое,
цитоплазма
базофильная,
молодая и наоборот.
89.
90.
91. ЭДТА-зависимый "тромбоцитарный сателлизм". тромбоциты связываются и образуют розетки вокруг лейкоцитов.
ЭДТА-зависимый "тромбоцитарный сателлизм".тромбоциты связываются и образуют розетки вокруг
лейкоцитов.
92. Основные функции системы крови:
• Кровь осуществляет в организме различныефункции. Она является транспортным
средством,
поддерживает
постоянство
«внутренней среды» организма (гомеостаз)
и играет главную роль в защите от
чужеродных
веществ.
93. Транспортная.
• Кровь переносит газы — кислород идиоксид углерода, а также питательные
вещества к печени и другим органам после
всасывания в кишечнике. Такой транспорт
обеспечивает снабжение органов и обмен
веществ в тканях, а также последующий
перенос конечных продуктов метаболизма
для их выведения из организма легкими,
печенью и почками. Кровь осуществляет
также перенос гормонов в организме.
94.
95. Гомеостаз.
• Кровь поддерживает водный балансмежду кровеносной системой, клетками
(внутриклеточным
пространством)
и
внеклеточной средой. Кислотно-основное
равновесие в крови регулируется легкими,
печенью
и
почками.
Поддержание
температуры тела также зависит от
контролируемого
кровью
транспорта
тепла.
96.
97. Защита
• Против чужеродных молекул и клеток,проникающих в организм, кровь обладает
неспецифическими и специфическими
механизмами защиты. К специфической
защитной системе относятся клетки
иммунной
системы
и
антитела.

medicine
medicine








